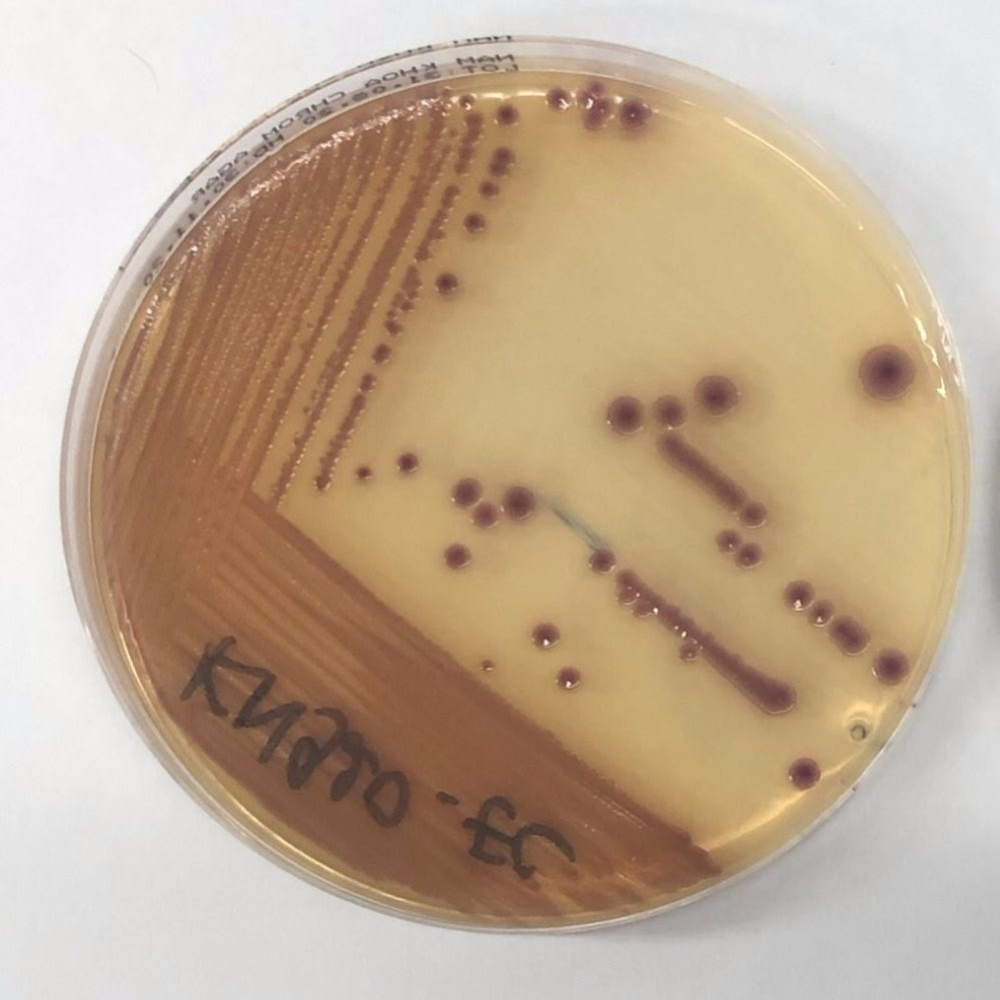

Đĩa Chromoagar Sàng Lọc Các Vi Khuẩn Đường Ruột Kháng Kháng Sinh Carbapenem
Đĩa Chromoagar sàng lọc các vi khuẩn đường ruột kháng kháng sinh Carbapenem (mã LIFVN-CNTB-009) là sản phẩm sinh phẩm chuẩn đoán nổi bật của Công ty TNHH MTV Sắc Mộc Tinh. Sản phẩm này cho phép phát hiện nhanh các vi khuẩn Gram âm có khả năng kháng thuốc Carbapenem thông qua màu sắc khuẩn lạc đặc trưng, đồng thời ức chế vi khuẩn Gram dương để tăng độ chọn lọc.
Giới thiệu sơ lược

Đĩa Chromoagar sàng lọc các vi khuẩn đường ruột kháng kháng sinh Carbapenem là sản phẩm sinh phẩm y tế do Công ty TNHH MTV Sắc Mộc Tinh phát triển. Với cơ chế tạo màu đặc trưng cho từng loại vi khuẩn Gram âm kháng Carbapenem, sản phẩm giúp nhận diện nhanh chóng, chính xác và dễ sử dụng trong vòng 16–24 giờ. Nhờ độ nhạy và độ đặc hiệu cao, đĩa Chromoagar là công cụ hữu ích cho các phòng xét nghiệm, bệnh viện trong việc sàng lọc và kiểm soát vi khuẩn kháng thuốc.
Thông tin về sản phẩm
- Mã số: LIFVN-CNTB-009
- Model: SMT-01
- Tên CN/TB chào bán: Đĩa chromoagar sàng lọc các vi khuẩn đường ruột kháng kháng sinh carbapenem
- Nơi có CN/TB chào bán: Công ty TNHH MTV Sắc Mộc Tinh
- Xuất xứ: Việt Nam
Thông số kỹ thuật
* Đĩa môi trường nuôi cấy vi khuẩn chọn lọc:
- Cho phép vi khuẩn Gram âm có tính kháng kháng sinh carbapenem (mức độ kháng từ trung bình đến cao)
- Ức chế các vi khuẩn Gram dương
- Định danh nhanh vi khuẩn Gram âm dựa theo màu sắc khuẩn lạc
* Chất lượng sinh phẩm:
- Độ nhạy 97.4%
- Độ đặc hiệu: 98.8%
* Hạn dùng & Bảo quản:
- 3 tháng
- Bảo quản lạnh ở 4 độ C
* Cách dùng:
- Sử dụng ngay sau khi đã để sinh phẩm đạt nhiệt độ phòng
- Sau khi cấy mẫu bệnh phẩm, ủ 37 độ C và đọc kết quả sau 16 - 24 giờ và định danh vi khuẩn theo màu khuẩn lạc điển hình.
Lĩnh vực áp dụng
Chẩn đoán sàng lọc tại các bệnh viện
Phương thức thương mại hóa

Bán sinh phẩm chẩn đoán
Bán quy trình can thiệp nhằm giảm tỷ lệ CRE lưu hành.
Mức độ phát triển
Hàng chỉ sản xuất khi có đặt hàng
Nhà máy sản xuất đạt chuẩn WHO GMP & ISO
Đã cung cấp cho các đơn vị:
Oxford University Clinical Research Unit tại Tp.HCM Việt Nam
National Center of Laboratory and Epidemiology tại Vientiane, Lào
Bệnh viện 199 / Bộ Công An tại Đà Nẵng, Việt Nam
Thông tin liên hệ
Công ty TNHH MTV Sắc Mộc Tinh
227/25 B Nguyễn Trọng Tuyển, P.8, Q.Phú Nhuận, Tp.HCM
72 Trần Bình Trọng, P.1, Q.Gò Vấp, Tp.HCM
Th.S Trần Chí Thành (Điện thoại: 0966.88.99.36)
Email: [email protected]